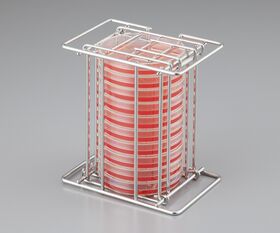

説明
【特徴】
●シャーレをまとめて逆さにできます。
●シャーレ収納後まとめて上下を逆さにし、インキュベータに入れることができるので効率よく菌検査ができます。
●開閉可能なフタが上下に付いているので、 どちらからでもシャーレが取り出せます。
【仕様】
●材質:ステンレス(SUS304)
●シャーレ収納数:10枚(シャーレ高さ:15mmの場合)
●適応シャーレ径:φ90mm
●サイズ(mm):145×100×157
●型番:STS-10
追加情報
メーカー名:
アズワン
メーカー品番:
STS-10
予定納期:
注文から1~3日で発送